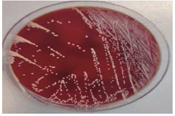

诺卡菌属放线菌目,主要存在于土壤、水源中,通过吸入肺部或者侵入创口而引起化脓性感染或肉芽肿性病变,也可以通过血液循环引起播散性感染,中枢神经系统是最常见的侵袭部位。现报道1例乔治教堂诺卡菌血培养阳性伴脑脓肿病例。本例患者有长期服用糖皮质激素史,其主要症状为咳嗽、咳痰伴发热,经复方磺胺甲噁唑联合头孢曲松治疗后好转。临床医师应提高对该疾病的认识,早期诊断,早期治疗。

版权归中华医学会所有。
未经授权,不得转载、摘编本刊文章,不得使用本刊的版式设计。
除非特别声明,本刊刊出的所有文章不代表中华医学会和本刊编委会的观点。
患者男,79岁,因"咳嗽、咳痰8 d,发热3 d"于2020年9月7日收入南京中医药大学附属南京中医院感染性疾病科。患者8 d前无明显诱因出现阵发性咳嗽、咳痰,痰色黄、质黏、难以咳出,伴气喘。3 d前,患者出现发热,最高体温达38.4 ℃,伴大小便失禁及呕吐胃内容物1次,至南京中医药大学附属南京中医院急诊科就诊。查血常规示白细胞计数为23.70×109/L,中性粒细胞比例为0.913,血红蛋白为134 g/L,血小板计数为210×109/L,CRP为73 mg/L。胸部CT检查示两肺气肿伴肺大疱形成,两肺间质性改变;左肺上叶团片影,考虑炎性病灶可能(图1A)。患者既往有心房颤动、心功能不全、慢性阻塞性肺疾病病史;有未分化结缔组织病病史1年余,长期服用泼尼松和雷公藤,泼尼松用量为5 mg/次,2次/d。入院后体格检查:体温为36.5 ℃,心率为75次/min,呼吸为20次/min,血压为98/62 mmHg(1 mmHg=0.133 kPa)。神志清楚,精神萎靡,淋巴结未及肿大。桶状胸,双肺呼吸音减弱,双下肺可闻及少量细湿啰音。心律不齐,未闻及病理性杂音。腹软,无压痛及反跳痛。双下肢无水肿。实验室检查示CRP为160 mg/L;ESR为102 mm/1 h;降钙素原为11.54 μg/L;脑钠肽为2 684 ng/L;铁蛋白>1 650 μg/L;白蛋白为19 g/L;EB病毒、CMV、β-D-葡聚糖试验、半乳甘露聚糖抗原试验、T细胞亚群、免疫五项(IgA、IgG、IgM、补体C3、补体C4)检查、T-SPOT.TB和PPD结果均为阴性。一般细菌痰涂片、痰涂片找抗酸杆菌、真菌涂片检查结果均为阴性。结合既往病史、辅助检查,考虑肺部细菌、真菌感染均不能排除,故予比阿培南(300 mg/次,4次/d)联合伏立康唑(200 mg/次,2次/d)静脉滴注抗感染治疗。9月14日(入院第8天)患者体温恢复正常,咳嗽、咳痰较前好转,胸部CT检查示肺部病灶较前吸收(图1B),血培养结果为乔治教堂诺卡菌阳性(图2),加用复方磺胺甲噁唑(磺胺甲噁唑/甲氧苄啶,800 mg/160 mg, 2次/d)。9月18日完善腹部和头颅MRI检查,结果回报左侧颞叶异常信号,考虑脓肿可能(图3A),余脏器未见血行播散病灶。患者感染乔治教堂诺卡菌,血行播散至脑形成脓肿,播散性诺卡菌病诊断明确,改用头孢曲松(2 g/次,2次/d)静脉滴注联合复方磺胺甲噁唑(2次/d)口服抗感染治疗1周后复查,血常规示白细胞计数为5.90×109/L,中性粒细胞比例为0.821,CRP<1 mg/L。患者临床症状和炎症指标较前明显好转,9月30日出院后序贯口服复方磺胺甲噁唑(2次/d)联合利奈唑胺(600 mg/次,2次/d),治疗10 d后复查血培养结果为阴性,10月14日复查头颅MRI示脑脓肿较前吸收(图3B)。10月27日复查头颅CT,提示病灶较前明显好转(图4)。2021年2月19日患者复查血培养结果为阴性,胸部CT检查示病灶较前吸收(图1C),头颅MRI检查示病灶已吸收完全,予复方磺胺甲噁唑减量(磺胺甲噁唑/甲氧苄啶,400 mg/80 mg, 3次/d)。








诺卡菌是一种需氧、革兰阳性、呈弱抗酸性的细菌,属放线菌目,主要存在于土壤、水源中,因此从事农业或户外工作的人群更易发生感染[1]。诺卡菌主要通过吸入肺部或者侵入创口而引起化脓性感染或肉芽肿性病变,也可以经血液循环引起播散性感染,其病死率高达40%[2],中枢神经系统是其最常见的侵袭部位,伴随脑脓肿出现,病死率进一步增长,在免疫功能低下的患者中病死率为55%[3]。作为一种条件致病菌,诺卡菌主要侵袭患有恶性肿瘤、HIV感染、肺部基础疾病,或曾接受器官移植、长期接受类固醇激素或免疫抑制剂治疗的人群。本例患者患有未分化结缔组织病,长期服用泼尼松,属于感染的高危人群。国内外关于诺卡菌菌血症的研究都证实免疫功能低下是患病的高危因素,Liang等[4]的研究中85.71%的患者曾服用糖皮质激素;Williams等[2]发现有81%的患者免疫功能低下,其中使用皮质类固醇激素者占49%。因皮质类固醇激素能抑制T淋巴细胞的功能,而T淋巴细胞既能直接作用于诺卡菌,又能激活巨噬细胞杀灭诺卡菌[5],所以长期服用皮质类固醇激素患者的T淋巴细胞杀灭诺卡菌和激活巨噬细胞的能力大大减弱,就成为诺卡菌感染的高危人群。
对人致病的诺卡菌主要有4种,分别为星形诺卡菌、豚鼠诺卡菌、巴西诺卡菌和鼻疽诺卡菌,其中以星形诺卡菌为主[6]。本例患者感染的乔治教堂诺卡菌属于星形诺卡菌属第Ⅵ型,在国内现有病例中感染率较高,且主要来源于肺部[7,8]。本例患者以咳嗽、咳痰、发热为主要表现,炎症指标升高,胸部CT检查示左肺上叶团片影,首先考虑肺部感染的可能,其临床表现和影像学表现均缺乏特异性,痰培养结果也为阴性,暂时无法明确病原学,且患者有长期、反复抗菌药物暴露史,故予经验性广谱抗菌药物治疗。虽然痰培养是明确病原学的常规检查手段,但在诺卡菌菌血症患者中呼吸道检出阳性率仅为22%[9],因此易被误诊、漏诊。与免疫功能正常的感染者相比,免疫功能低下的患者更易出现血行播散,侵犯中枢神经系统形成脑脓肿[9],所以当本例患者血培养提示乔治教堂诺卡菌时,立即完善了头颅及腹部MRI检查,进一步明确有无播散病灶。
诺卡菌繁殖速度较慢,一般需1周才可见菌落,传统方法培养时间不足易造成漏诊,本例患者血培养阳性也是于检测1周后才得到结果,所以选择快速而准确的诊断方法至关重要。目前齐-内(Ziehl-Neelsen)染色联合宏基因组学第二代测序、PCR都被认为有利于提高诺卡菌病诊断的效率及准确性[10,11]。
根据相关指南,诺卡菌的抗菌药物敏感性不尽相同,建议进行抗菌药物敏感性试验,以便更准确地指导用药[12]。总体而言,诺卡菌属对复方磺胺甲噁唑、阿米卡星、亚胺培南、利奈唑胺、第三代头孢菌素等敏感[13]。乔治教堂诺卡菌的药物敏感试验结果与之大致相符[7,13]。治疗诺卡菌血行性脓肿的首选治疗方案可参照《热病:桑德福抗微生物治疗指南》[14],推荐使用磺胺甲噁唑联合亚胺培南。多器官受累者加用阿米卡星,静脉滴注3~6周后改为序贯口服。免疫抑制患者需2种药物联合治疗至少1年。本例患者诺卡菌菌血症诊断明确,且伴有脑脓肿,需使用具有较好血脑屏障通透性的药物,故予复方磺胺甲噁唑联合头孢曲松抗感染治疗,并序贯口服复方磺胺甲噁唑联合利奈唑胺,之后取得较好疗效。
目前国内对于诺卡菌感染的病例报道仍不多见,尽早明确诊断并制订最优诊疗方案,以及足疗程治疗是治疗该病的关键。相较于20年前,诺卡菌感染者的病死率并没有显著降低,说明临床医师对该疾病的认识亟待提高。对于伴有肺部基础疾病、免疫功能低下且长期服用皮质类固醇激素的患者,当出现发热、咳嗽、咳痰,甚至头痛、恶心、呕吐或意识障碍时,应警惕诺卡菌感染的可能性,尽快完善相关病原学检查,进行及时、有效的治疗。
所有作者均声明不存在利益冲突